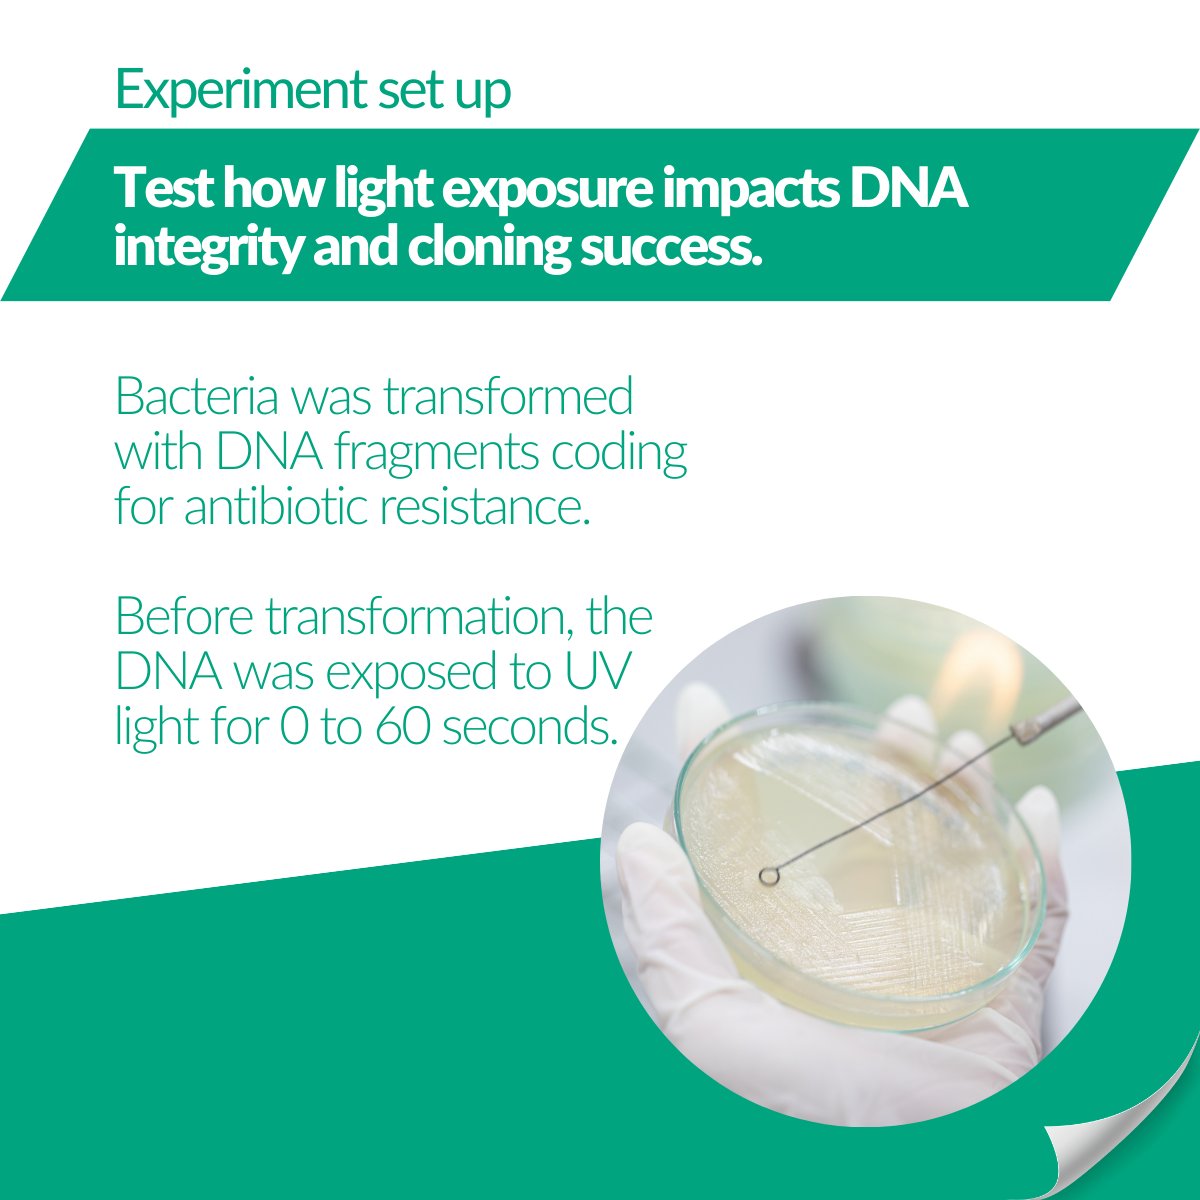
NipponGenEU's tweet image. 🧬When it comes to 𝗗𝗡𝗔 𝗶𝗻𝘁𝗲𝗴𝗿𝗶𝘁𝘆, the light you use matters.
Skip the harm, skip the fuss - Blue/Green LED is the light you can trust!
#LabInnovation #MolecularBiology #BlueGreenLED

#bluegreenled search results
🧬When it comes to 𝗗𝗡𝗔 𝗶𝗻𝘁𝗲𝗴𝗿𝗶𝘁𝘆, the light you use matters. Skip the harm, skip the fuss - Blue/Green LED is the light you can trust! #LabInnovation #MolecularBiology #BlueGreenLED




Discover our customers' voices using our FastGene® FAS-DIGI PRO. Convinced? Request a demo: nippongenetics.eu/en/product-inq… See it to believe it! #BlueGreenLED #geldocumentationsystem #DNA #RNA #fluorescentdyes #labequipment #FastGene




𝗢𝘂𝗿 𝗕𝗹𝘂𝗲/𝗚𝗿𝗲𝗲𝗻 𝗟𝗘𝗗 𝘁𝗲𝗰𝗵𝗻𝗼𝗹𝗼𝗴𝘆 𝘀𝗵𝗶𝗻𝗲𝘀 𝗯𝗿𝗶𝗴𝗵𝘁! To discover our range of Blue/Green LED products, visit the following link: nippongenetics.eu/en/product-cat…. See it to believe it! @BOKUvienna #BlueGreenLED #geldocumentationsystem #fluorescentdyes

🔬 The number of scientists switching to Blue/Green LED technology is growing every day, and it's amazing to witness this shift toward safer research! Medical University Innsbruck nippongenetics.eu/en/product-cat… #GelImaging #BlueGreenLED #LabSafety #HappyCustomers #MolecularBiology

Nippon Genetics Europe is now at the Conference of the ASSOCIATION for GENERAL and #APPLIED #MICROBIOLOGY in Wolfsburg, Germany. Visit our booth 22 and get some great insight about our unique #BlueGreenLED technology and our fancy #UltraCycler. #Nippon #Genetics #Europe




Day 24: 24 LEDs that make FAS-X unstoppable! The FastGene® FAS-X is equipped with 24 LEDs, combining innovative technology with brilliant performance. These LEDs ensure safer imaging, making it a favorite for labs worldwide. #LabEquipment #Awardwinning #BlueGreenLED
🔬 The number of scientists switching to Blue/Green LED technology is growing every day, and it's amazing to witness this shift toward safer research! Medical University Innsbruck nippongenetics.eu/en/product-cat… #GelImaging #BlueGreenLED #LabSafety #HappyCustomers #MolecularBiology

Day 24: 24 LEDs that make FAS-X unstoppable! The FastGene® FAS-X is equipped with 24 LEDs, combining innovative technology with brilliant performance. These LEDs ensure safer imaging, making it a favorite for labs worldwide. #LabEquipment #Awardwinning #BlueGreenLED
🧬When it comes to 𝗗𝗡𝗔 𝗶𝗻𝘁𝗲𝗴𝗿𝗶𝘁𝘆, the light you use matters. Skip the harm, skip the fuss - Blue/Green LED is the light you can trust! #LabInnovation #MolecularBiology #BlueGreenLED




𝗢𝘂𝗿 𝗕𝗹𝘂𝗲/𝗚𝗿𝗲𝗲𝗻 𝗟𝗘𝗗 𝘁𝗲𝗰𝗵𝗻𝗼𝗹𝗼𝗴𝘆 𝘀𝗵𝗶𝗻𝗲𝘀 𝗯𝗿𝗶𝗴𝗵𝘁! To discover our range of Blue/Green LED products, visit the following link: nippongenetics.eu/en/product-cat…. See it to believe it! @BOKUvienna #BlueGreenLED #geldocumentationsystem #fluorescentdyes

Discover our customers' voices using our FastGene® FAS-DIGI PRO. Convinced? Request a demo: nippongenetics.eu/en/product-inq… See it to believe it! #BlueGreenLED #geldocumentationsystem #DNA #RNA #fluorescentdyes #labequipment #FastGene




Nippon Genetics Europe is now at the Conference of the ASSOCIATION for GENERAL and #APPLIED #MICROBIOLOGY in Wolfsburg, Germany. Visit our booth 22 and get some great insight about our unique #BlueGreenLED technology and our fancy #UltraCycler. #Nippon #Genetics #Europe




🧬When it comes to 𝗗𝗡𝗔 𝗶𝗻𝘁𝗲𝗴𝗿𝗶𝘁𝘆, the light you use matters. Skip the harm, skip the fuss - Blue/Green LED is the light you can trust! #LabInnovation #MolecularBiology #BlueGreenLED

#labequipment #bluegreenled #dnaanalysis #rnaanalysis #proteindetection #lifescience #molecularbiology #safescience #nippongenetics #researchlab #gelimaging #labtechnology

🔬 The number of scientists switching to Blue/Green LED technology is growing every day, and it's amazing to witness this shift toward safer research! Medical University Innsbruck nippongenetics.eu/en/product-cat… #GelImaging #BlueGreenLED #LabSafety #HappyCustomers #MolecularBiology

Discover our customers' voices using our FastGene® FAS-DIGI PRO. Convinced? Request a demo: nippongenetics.eu/en/product-inq… See it to believe it! #BlueGreenLED #geldocumentationsystem #DNA #RNA #fluorescentdyes #labequipment #FastGene




Nippon Genetics Europe is now at the Conference of the ASSOCIATION for GENERAL and #APPLIED #MICROBIOLOGY in Wolfsburg, Germany. Visit our booth 22 and get some great insight about our unique #BlueGreenLED technology and our fancy #UltraCycler. #Nippon #Genetics #Europe




𝗢𝘂𝗿 𝗕𝗹𝘂𝗲/𝗚𝗿𝗲𝗲𝗻 𝗟𝗘𝗗 𝘁𝗲𝗰𝗵𝗻𝗼𝗹𝗼𝗴𝘆 𝘀𝗵𝗶𝗻𝗲𝘀 𝗯𝗿𝗶𝗴𝗵𝘁! To discover our range of Blue/Green LED products, visit the following link: nippongenetics.eu/en/product-cat…. See it to believe it! @BOKUvienna #BlueGreenLED #geldocumentationsystem #fluorescentdyes

Something went wrong.
Something went wrong.
United States Trends
- 1. Mike Malone N/A
- 2. Angel Reese N/A
- 3. Dexter Lawrence N/A
- 4. Invited Users N/A
- 5. #ArtemisII N/A
- 6. Billy Donovan N/A
- 7. Goldust N/A
- 8. PRESALE IS NOW OPEN N/A
- 9. PRESALE HAS NOW LAUNCHED N/A
- 10. THE PRESALE EVENT HAS STARTED N/A
- 11. PUBLIC PRESALE IS NOW LIVE N/A
- 12. #Always_Together_With_sevEN N/A
- 13. TOKEN PRESALE HAS BEGUN N/A
- 14. PRESALE IS OFFICIALLY LIVE N/A
- 15. PRESALE ACCESS IS NOW OPEN N/A
- 16. Atlanta N/A
- 17. THE PRESALE WINDOW IS NOW OPEN N/A
- 18. #Together_We_BOYCOTT_BELIFT N/A
- 19. Nutella N/A
- 20. Apollo 13 N/A



